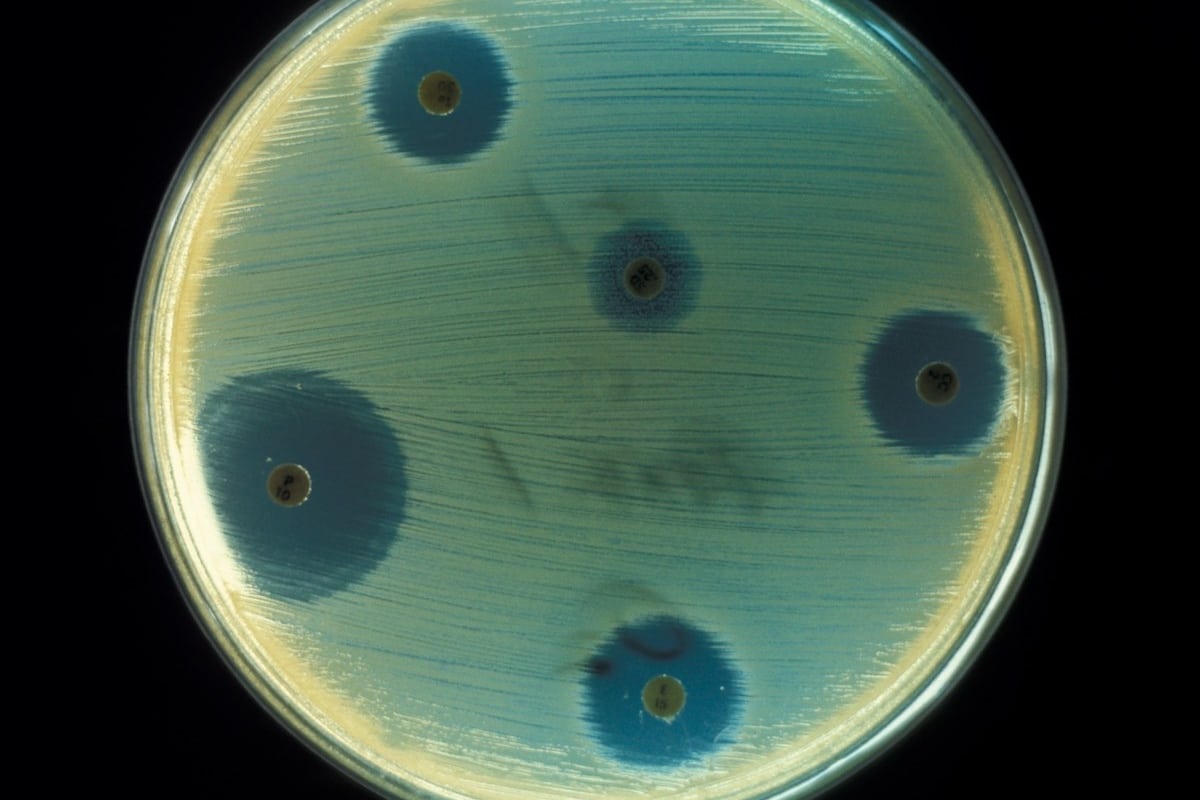

Pour tester la sensibilité des bactéries aux antibiotiques, on fait pousser les bactéries en présence d’antibiotiques (les antibiotiques sont ces petits disques sur l’image). Ici, on a cultivé Staphyloccoccus aureus. On peut ensuite déterminer si les bactéries sont sensibles à l’antibiotique. Si les bactéries sont sensibles, elles ne réussissent pas à pousser et le pourtour du disque est ainsi clair. Dans l’image, on voit que le cercle plus grand à gauche. Image: CDC
Des experts s’inquiètent des microbes résistants aux antibiotiques, une menace qui pourrait prendre de l’ampleur dans l’ombre de la pandémie de COVID-19.
Toute l’attention portée à la COVID-19 nous détourne d’autres infections qui continuent de proliférer. C’est l’inquiétude, entre autres, de deux chercheurs de l’Université du Queensland, en Australie, qui ont signé une lettre dans la revue Science en janvier dernier. Ils y mentionnent que l’usage massif de désinfectants pour prévenir la transmission de la COVID-19 pourrait offrir du même coup un milieu propice à l’émergence de microbes résistants aux antibiotiques (comme les bactéries et les levures résistantes aux traitements).
«Contrairement aux virus, qui ne peuvent pas se reproduire de manière indépendante et survivent rarement dans l’environnement, les bactéries peuvent proliférer et possiblement acquérir une résistance antimicrobienne», écrivent-ils.
En effet, l’usage de désinfectants semble faciliter le transfert de certains gènes entre les microorganismes, notamment ceux qui confèrent aux bactéries une résistance à certains antibiotiques.
Parallèlement, la consommation d’antibiotiques est en hausse depuis le début de la pandémie, ceux-ci étant fréquemment administrés aux patients atteints de la COVID-19. Dans une revue de littérature parue en novembre dernier dans le journal Clinical Infectious Diseases, des scientifiques britanniques ont examiné 85 études qui comprenaient 2 010 patients hospitalisés pour la COVID-19. De ce lot, 72 % ont reçu des antibiotiques contre une possible infection bactérienne ou fongique alors que seulement 8% avaient véritablement une co-infection.
Jusqu’à présent, toutefois, comme le signale un éditorial dans Eurosurveillance, les données ne sont pas assez à jour pour permettre d’évaluer l’impact de la COVID-19 sur l’antibiorésistance. Les bactéries comme les Staphylococcus aureus résistants à la méthicilline (SARM) et les entérocoques résistants à la vancomycine (ERV) font partie des plus redoutées dans les milieux hospitaliers. «On est préoccupés par les SARM et les ERV dont on continue de faire le suivi. C’est sûr que les données sont plus difficiles à obtenir parce que les gens sont tellement mobilisés par la COVID-19. Mais jusqu’à présent, on n’a pas eu de problèmes majeurs dans les hôpitaux», assure le Dr Jasmin Villeneuve, de l’Institut national de la santé publique du Québec (INSPQ).
Avant même le début de la pandémie, la résistance aux antibiotiques était considérée comme l’une des plus grandes menaces en santé publique. Selon un rapport du gouvernement britannique cité par l’Organisation mondiale de la Santé, «on estime que d’ici 2050, l’antibiorésistance sera responsable de la mort de 10 millions de personnes et, en outre, coûtera jusqu’à 100 000 milliards de dollars US.»
Et les infections fongiques?
Il n’y a pas que les bactéries résistantes qui préoccupent les autorités sanitaires. Une levure qui peut causer des infections chez les patients ayant un système immunitaire affaibli, Candida auris, est elle aussi difficile à éradiquer. Elle résiste à l’assaut de plusieurs antifongiques et persiste longtemps sur les surfaces.
Ce microbe a été identifié pour la première fois en 2009. Pendant la pandémie de COVID-19, des éclosions isolées ont été remarquées en Inde, aux États-Unis, au Royaume-Uni, au Brésil… Aux États-Unis, les Centres pour le contrôle et la prévention des maladies (CDC) ont été alertés par une éclosion d’une trentaine de cas de C. auris dans une unité dédiée à la COVID-19 dans un hôpital de la Floride. Les enquêteurs du CDC ont remarqué que les éclosions ont été favorisées par l’utilisation prolongée du matériel de protection et le manque de nettoyage et de désinfection. Après avoir remédié à la situation, l’hôpital n’a pas détecté d’autres cas.
Cette situation démontre qu’il faut rester vigilant face aux infections nosocomiales, comme le mentionne le Dr Jasmin Villeneuve, de l’INSPQ. Depuis la découverte de C. auris, il y a eu jusqu’à présent 2 cas connus au Québec: un en 2012, l’autre en 2020. Ces cas ont été importés de l’étranger et n’ont pas donné lieu à des éclosions dans les milieux hospitaliers.
«L’enjeu avec C. auris, c’est que l’on peut être porteur sans avoir de symptômes. On risque donc d’identifier l’infection lors d’analyses de laboratoire réalisées pour d’autres problèmes de santé», rapporte le Dr Villeneuve.







